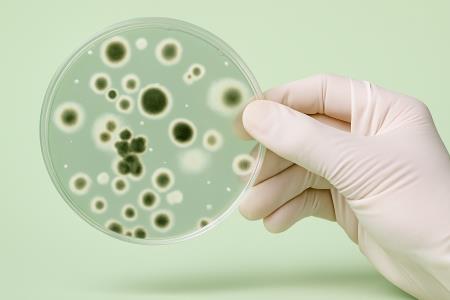

Datum: 18.6.2022 - Rubrika:
Dobro je vedeti
Zakaj je poleti nevarno piti vodo v plastenki iz avta?
Avtor:
uredništvo Vem, kaj jem
Vsakdo ima poleti v avtu kakšno plastenko vode, ki pa je lahko zelo nevarna. Nikar ne pijte takšne vode.
Članek je bil ustvarjen leta 2022, letos smo že preverili nekatera dejstva, preostali del pa bomo kmalu še dopolnili in nadgradili. Trudimo se, da bi bili članki na Vem, kaj jem ažurirani z najnovejšimi dognanji. Sodobna znanost namreč skoraj vsak dan odkrije kaj novega ...
Ko zunanja temperatura zraka doseže 30 stopinj Celzija ali več, potem bo temperatura v avtu v samo pol ure narasla na 45 stopinj in več. Če pa avto stoji na soncu eno uro, potem je lahko v njem 50, pa tudi 70 stopinj Celzija. To pa so že ekstremni pogoji, ko se iz plastične plastenke začno izločati nevarne snovi.
Gre predvsem za bisfenol A in antimon, ki sta dokazano nevarna za zdravje že v zelo majhnih količinah.
Bisfenol A ima v telesu podoben učinek kot estrogen. Povzroča hormonska neskladja, cela vrsta raziskav pa ga povezuje še z drugimi boleznimi, kot so bolezni ščitnice in celo diabetes.
Antimon je belo-modra polkovina, ki jo je mednarodna agencija za raziskavo raka IARC razvrstila v skupino 2B, kar pomeni, da lahko povzroča raka. Predvsem problematično je njegovo izločanje pri visokih temperaturah. Prisotnost antimona prepoznate tudi tako, da je plastenka brez te nevarne snovi trša.
Bisfenol A (kratica BPA) prav tako spada med potencialno nevarne snovi, čeprav mnogi zatrjujejo, da znanstvenega dokaza o njegovih nevarnih učinkih ni. Še več. Bisfenol A se uporablja celo pri nekaterih zdravilih. Najbolj nenavadno je, da bisfenol dokazano škodi ribam, vodnim vretenčarjem, dvoživkam in plazilcem. Določeno stopnjo toksičnosti so z raziskavami zaznali tudi pri podganah. Pri ljudeh neposredne povezave (še?) ni.
Pa vendar, mar ni dovolj, da s plastiko zastrupljamo ribe?! Ste kdaj pomislili, koliko zastrupljenih rib ste pojedli v življenju?
Še to si velja zapomniti: poleti ne jejte nobenih živil, ki so bila več kot pol ure zaprta v avtu, ki je stal na soncu. Četudi gre za običajen sendvič, ali sadje v plastični vrečki.
Gre predvsem za bisfenol A in antimon, ki sta dokazano nevarna za zdravje že v zelo majhnih količinah.
Bisfenol A ima v telesu podoben učinek kot estrogen. Povzroča hormonska neskladja, cela vrsta raziskav pa ga povezuje še z drugimi boleznimi, kot so bolezni ščitnice in celo diabetes.
Antimon je belo-modra polkovina, ki jo je mednarodna agencija za raziskavo raka IARC razvrstila v skupino 2B, kar pomeni, da lahko povzroča raka. Predvsem problematično je njegovo izločanje pri visokih temperaturah. Prisotnost antimona prepoznate tudi tako, da je plastenka brez te nevarne snovi trša.
Bisfenol A (kratica BPA) prav tako spada med potencialno nevarne snovi, čeprav mnogi zatrjujejo, da znanstvenega dokaza o njegovih nevarnih učinkih ni. Še več. Bisfenol A se uporablja celo pri nekaterih zdravilih. Najbolj nenavadno je, da bisfenol dokazano škodi ribam, vodnim vretenčarjem, dvoživkam in plazilcem. Določeno stopnjo toksičnosti so z raziskavami zaznali tudi pri podganah. Pri ljudeh neposredne povezave (še?) ni.
Pa vendar, mar ni dovolj, da s plastiko zastrupljamo ribe?! Ste kdaj pomislili, koliko zastrupljenih rib ste pojedli v življenju?
Še to si velja zapomniti: poleti ne jejte nobenih živil, ki so bila več kot pol ure zaprta v avtu, ki je stal na soncu. Četudi gre za običajen sendvič, ali sadje v plastični vrečki.
Vsebina je informativne narave in ne nadomešča nasveta zdravnika.
vkj
O AVTORJU:
Članek je uredniško pregledal Zvone Štor, ki sicer nima formalne nutricionistične izobrazbe, a že vrsto let pa spremlja tende na področju zdrave hrane in zdravega načina življenja. Članek ni zdravniški nasvet.
Članek je uredniško pregledal Zvone Štor, ki sicer nima formalne nutricionistične izobrazbe, a že vrsto let pa spremlja tende na področju zdrave hrane in zdravega načina življenja. Članek ni zdravniški nasvet.
Avtomobilska plastenka in zdravstvene težave
Bisfenol A in antimon
Nevarnost pitja vode iz plastenke v avtu
Toksičnost plastike za zdravje
Visoke temperature in plastenke

* Na ta naslov vam bomo pošiljali samo e-bilten enkrat na teden. Odjavite se lahko kadarkoli.

Zdravje, lepota
Redkvica: vitaminska bomba in kraljica zdravja
Redkvice so zaklad narave, ki ga ne smete prezreti. Če bi vedeli, kaj vse skriva v sebi, bi jo jedli celo leto, če bi to le bilo mogoče.
VEČ >

Zdravje, lepota
Olivno olje na prazen želodec: zdrava navada ali mit?
VEČ >

Dobro je vedeti
30-sekundni test zdravja, da boste vedeli, kaj jesti
VEČ >

Dobro je vedeti
Zakaj je poleti nevarno piti vodo v plastenki iz avta?
VEČ >
Dobro je vedeti
10 znakov, da imate preveč glivic Candide
VEČ >

Zdravje, lepota
6 razlogov, zakaj bi morali občasno piti alkohol
Pretirano uživanje alkohola je povezano s številnimi zdravstvenimi težavami, od težav z jetri do zasvojenosti. Zmerno uživanje pa je povsem drugačna zgodba ...
VEČ >

Zdravje, lepota
5 vzrokov raka, ki bi jih morali odstraniti iz svojega doma
VEČ >

Dobro je vedeti
Živila, ki preprečujejo napenjanje
VEČ >

Zdravje, lepota
Kako zdravo je uživati rumenjake?
VEČ >

Zdravje, lepota
Kako lažje vstati: brez nejevolje in z več energije
VEČ >
Naložite mobilno aplikacijo:

Poslikajte hrano in spremljate kalorije, beljakovine, vlaknine, ogljikove hidrate in maščobe. Naj bo vaša prehrana bolj uravnotežena ...
Več o aplikaciji najdete TUKAJ





















